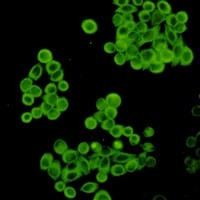
CYP2D6 Antibody in Immunocytochemistry (ICC/IF)

Search
Abnova
CYP2D6 Recombinant Rabbit Monoclonal Antibody
{{$productOrderCtrl.translations['antibody.pdp.commerceCard.promotion.promotions']}}
{{$productOrderCtrl.translations['antibody.pdp.commerceCard.promotion.viewpromo']}}
{{$productOrderCtrl.translations['antibody.pdp.commerceCard.promotion.promocode']}}: {{promo.promoCode}} {{promo.promoTitle}} {{promo.promoDescription}}. {{$productOrderCtrl.translations['antibody.pdp.commerceCard.promotion.learnmore']}}
图: 1 / 3
CYP2D6 Antibody (RAB02584) in ICC/IF



产品信息
RAB02584
种属反应
宿主/亚型
Expression System
分类
类型
偶联物
形式
纯化类型
保存液
内含物
保存条件
运输条件
靶标信息
Cytochrome p450 2D6 (CYP2D6) is a member of the cytochrome P450 superfamily of enzymes. The cytochrome P450 proteins are monooxygenases which catalyze many reactions involved in drug metabolism and synthesis of cholesterol, steroids and other lipids. This protein localizes to the endoplasmic reticulum and is known to metabolize as many as 20% of commonly prescribed drugs. Its substrates include debrisoquine, an adrenergic-blocking drug; sparteine and propafenone, both anti-arrythmic drugs; and amitryptiline, an anti-depressant. The gene is highly polymorphic in the population; certain alleles result in the poor metabolizer phenotype, characterized by a decreased ability to metabolize the enzyme's substrates. The gene is located near two cytochrome P450 pseudogenes on chromosome 22q13.1. Alternatively spliced transcript variants encoding different isoforms have been found for this gene.
仅用于科研。不用于诊断过程。未经明确授权不得转售。
篇参考文献 (0)
生物信息学
蛋白别名: Cholesterol 25-hydroxylase; CYP2D6; CYPIID6; Cytochrome P450 2D6; cytochrome P450, family 2, subfamily D, polypeptide 6; cytochrome P450, family 2, subfamily D, polypeptide 7 pseudogene 2; cytochrome P450, family 2, subfamily D, polypeptide 8 pseudogene 2; cytochrome P450, subfamily II (debrisoquine, sparteine, etc., -metabolising), polypeptide 7 pseudogene 2; cytochrome P450, subfamily IID (debrisoquine, sparteine, etc., -metabolising), polypeptide 8 pseudogene 2; cytochrome P450, subfamily IID (debrisoquine, sparteine, etc., -metabolizing), polypeptide 6; cytochrome P450, subfamily IID (debrisoquine, sparteine, etc., -metabolizing)-like 1; Cytochrome P450-DB1; Debrisoquine 4-hydroxylase; flavoprotein-linked monooxygenase; microsomal monooxygenase; nonfunctional cytochrome P450 2D6; xenobiotic monooxygenase
基因别名: CPD6; CYP2D; CYP2D6; CYP2D7AP; CYP2D7BP; CYP2D7P2; CYP2D8P2; CYP2DL1; CYPIID6; P450-DB1; P450C2D; P450DB1
UniProt ID: (Human) P10635
Entrez Gene ID: (Human) 1565